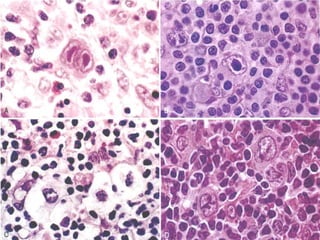

Hodgkin lymphoma is a type of lymphoid neoplasm distinguished by the presence of Reed-Sternberg cells, typically presenting in young adults with symptoms such as painless swelling of lymph nodes, weight loss, high fevers, and night sweats. It is classified into various subtypes, including classical Hodgkin lymphoma and lymphocyte-predominant Hodgkin lymphoma, with different prognoses and cellular characteristics. The disease is usually localized but can spread to contiguous lymph nodes and has a bimodal incidence peak in young adults and older populations.